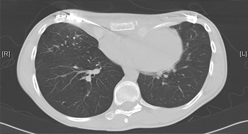

Leistungsspektrum
Im Folgenden soll eine Auswahl der Standoperationen sowie neuerer Techniken gegeben werden, die am Universitären Lungenzentrum angeboten werden.
Routineverfahren:
-

Operationen bei Lungenkrebs und anderen Tumoren des Brustraumes
Alle Operationsverfahren bei gut- und bösartigen Tumoren der Lunge werden angeboten,...
mehr lesen -

Operationen und interventionen bei Lungenmetastasen
In Abhängigkeit vom Primärtumor, vor allem aber von der Lokalisation der Metastasen werden die genannten operativen Verfahren angeboten...
mehr lesen -

Tracheachirurgie
Resektionen von Trachealtumoren oder Trachealeinengungen über möglichst schonende Zugangswege...
mehr lesen
-

Zwerchfellchirurgie
Plastische Wiederherstellung des Zwerchfells bei Zwerchfellhochstand...
mehr lesen
-

Operationen bei Pleuraerguss/Pneumothorax/ Lungenemphysem
Videoassistierte Entfernung einzelner Lungenblasen (Bullae) bei Pneumothorax dienen der Prophylaxe vor einem Rezidiv, d.h. Wiederauftreten des Lungenkollaps...
mehr lesen -

Spetische Thoraxchirurgie
Bei Eiteransammlungen im Pleuraraum oder anderen Infektionen werden diese in Abhängigkeit vom Stadium der Erkrankung...
mehr lesen
Neuere Operationstechniken:
-
Minimal-Invasive Operationen bei Trichterbrust
Die kosmetisch-plastische Korrektur erfolgt mit einem selbst entwickelten, neuartigen Verfahren über zwei kurze Hautschnitte...
mehr lesen
-

Hyperthermie Chemotherapie
Bei bestimmten Tumorerkrankungen kann eine lokale Chemotherapie unter Erwärmung des Gewebes einen zusätzlichen Nutzen....
mehr lesen
-

Roboterchirurgie
Im Februar 2011 wurde die Entfernung eines ganzen Lungenlappens bei Lungenkrebs über eine „Schlüssellochtechnik“ mit dem daVinci...
mehr lesen
